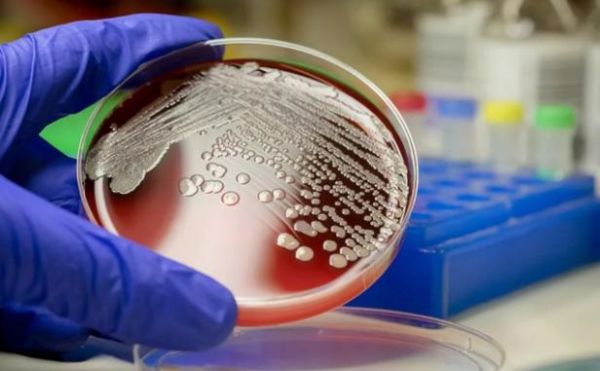
微生物技术就业前景怎么样_微生物专业能做什么工作

微生物技术就业前景怎么样?一句话:需求持续增长,岗位多元且薪酬可观。
行业需求:谁在大量招聘微生物人才?
过去五年,国内“微生物”相关职位发布量年均增长18%。招聘主力集中在以下四大板块:
- 生物医药企业:疫苗、抗体药、细胞治疗公司,对发酵工艺、GMP质控人才需求最旺。
- 食品与保健品:益生菌、发酵乳、功能配料厂商,需要微生物安全与功能评价专家。
- 环境工程:市政污水、工业废水、土壤修复项目,微生物群落设计岗位缺口大。
- 合成生物学初创:利用工程菌生产高值化学品,招聘菌种工程师、代谢通路设计师。
薪酬地图:不同城市的真实薪资区间
| 城市等级 | 岗位示例 | 年薪范围(万元) |
|---|---|---|
| 一线城市 | 疫苗上游工艺科学家 | 25–45 |
| 新一线 | 益生菌研发工程师 | 18–30 |
| 二三线 | 污水厂微生物技术员 | 10–18 |
值得注意的是,掌握高通量筛选、CRISPR基因编辑、生物信息分析三项技能之一,薪资可再上浮20%–40%。
职业路径:从实验室到管理层的晋升阶梯
技术序列
实验员 → 项目负责人 → 首席科学家
生产序列
工艺员 → 车间主任 → 生产总监
市场序列
技术支持 → 产品经理 → 事业部总经理

自问:必须读博才能晋升吗?
自答:并非。企业更看重项目经验与解决实际问题的能力,硕士+三年产业经验往往比纯博士更吃香。
必备技能:HR最常提到的“硬通货”
- 无菌操作与发酵罐控制:能独立处理50L–500L规模实验。
- 微生物组学分析:熟悉QIIME、R、Python至少一种生信流程。
- 法规与注册:了解中国药典、FDA/EMA申报资料撰写要点。
- 跨学科沟通:能把菌株代谢通路用PPT讲给投资人听懂。
深造or就业?两条路线的利弊对比
直接就业
- 利:提前积累产业经验,经济独立。
- 弊:晋升到高级研发岗时可能遇到学历天花板。
攻读硕博
- 利:进入高校、科研院所或担任企业首席科学家机会更大。
- 弊:机会成本高,若研究方向与产业脱节,反而降低竞争力。
自问:如何判断自己是否适合读博?
自答:如果对探索未知机制充满热情,且能忍受三到五年较低收入,可考虑;若更享受把技术快速变成产品,直接就业更划算。
未来五年最值得关注的细分赛道
活体生物药(LBP)
利用工程菌治疗肠道炎症、肿瘤,2025年全球市场规模预计突破80亿美元。

微生物组诊断
通过粪便菌群预测糖尿病、抑郁症风险,国内已有三家初创完成B轮融资。
噬菌体疗法
针对超级细菌,替代传统抗生素,政策窗口正在打开。
二氧化碳固定菌
把工业尾气转化为乙醇、蛋白饲料,碳中和概念下资本疯狂涌入。
求职实战:如何三个月内拿到心仪offer
步骤一:精准定位——在招聘网站用“微生物+合成生物学”“微生物+疫苗工艺”双重关键词过滤,锁定20家目标公司。
步骤二:项目包装——把毕业论文或实习经历拆解成“问题-方法-结果-商业价值”四段式,用数据说话。
步骤三:技能补洞——若缺乏发酵经验,可报名线上虚拟仿真平台,两周内获得操作证书。
步骤四:内推+猎头——在LinkedIn、小木虫、脉脉找到校友,内推成功率提升3倍。
常见误区:别让这些认知拖慢你的脚步
- 误区一:微生物=脏累差——现代发酵车间洁净度可达制药级,全程自动化。
- 误区二:女生不适合——事实上,女性在无菌操作、细致记录方面更具优势,多家药企发酵部门女员工占比超60%。
- 误区三:只能待在实验室——市场、注册、投资岗位同样需要微生物背景,且晋升更快。
资源清单:持续提升竞争力的免费渠道
在线课程:Coursera《Microbiology and Immunology》、B站“合成生物学公开课”
专业社区:微生物组创新创业者协会、丁香园“微生物与感染”论坛
必读报告:麦肯锡《Bio Revolution 2023》、CB Insights《State of Microbiome 2024》
工具网站:NCBI Microbial Genomes、IMG/M 数据平台
尾声:抓住政策与资本的双重红利
“十四五”生物经济发展规划把微生物制造列为核心攻关方向,国家制造业转型升级基金已明确向发酵技术倾斜。对个体而言,现在上车,相当于十年前加入互联网。把技能树点满,把简历打磨锋利,微生物专业的黄金时代才刚刚开始。
评论列表